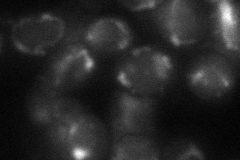
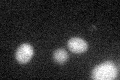

View description
Major ADP/ATP carrier of the mitochondrial inner membrane, exchanges cytosolic ADP for mitochondrially synthesized ATP; phosphorylated; required for viability in many common lab strains carrying a mutation in the polymorphic SAL1 gene
Localization:
Intensity:
Fold change:
Significance:
-
C’ GFP library in SD

below threshold14.24 -
N' NOP1pr-GFP in SD

mitochondria260.709 -
N' TEF2pr-mCherry in SD

missing0 -
N' NATIVEpr-GFP in SD

below threshold21.2358 -
N' TEF2pr-VC and Cyto-VN in SD
mitochondria44.0075 -
C’ GFP library in SD+DTT
cytosol15.541.09No -
C’ GFP library in SD+H2O2

cytosol13.470.94No -
C’ GFP library in Starvation Media

cytosol16.051.12No -
C’ GFP library on the background of Pup2-DaMP

N/A -
C’ GFP library on the background of CCT mutant

N/A0N/AYes
